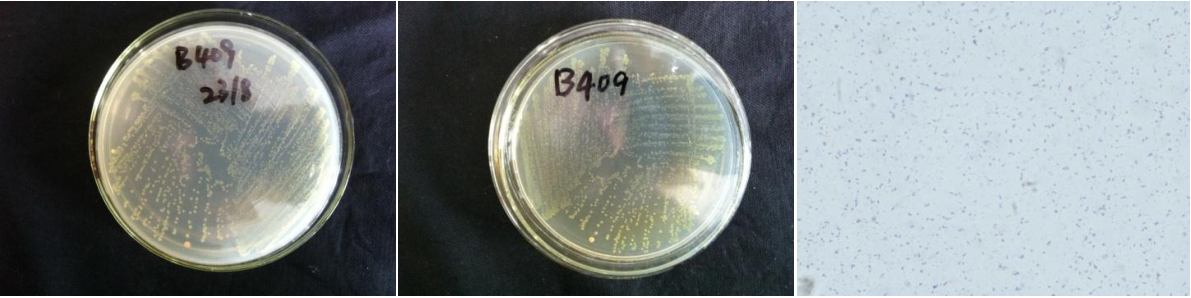

Loading...
| StrainNO | B409 |
| Classification | Bacillus |
| 16s rDNA sequence | CACCGGGTCCACCTTCGGCGGCTGGCTCCTAAAGGTTACCTCACCGACTTCGGGTGTTACAAACTCTCGTGGTGTGACGGGCGGT GTGTACAAGGCCCGGGAACGTATTCACCGCGGCATGCTGATCCGCGATTACTAGCGATTCCAGCTTCACGCAGTCGAGTTGCAGA CTGCGATCCGAACTGAGAACAGATTTGTGGGATTGGCTTAACCTCGCGGTTTCGCTGCCCTTTGTTCTGTCCATTGTAGCACGTG TGTAGCCCAGGTCATAAGGGGCATGATGATTTGACGTCATCCCCACCTTCCTCCGGTTTGTCACCGGCAGTCACCTTAGAGTGCC CAACTGAATGCTGGCAACTAAGATCAAGGGTTGCGCTCGTTGCGGGACTTAACCCAACATCTCACGACACGAGCTGACGACAACC ATGCACCACCTGTCACTCTGCCCCCGAAGGGGAAGTCCTATCTCTAGGATTGTCAGAGGATGTCAAGACCTGGTAAGGTTCTTCG CGTTGCTTCGAATTAAACCACATGCTCCACCGCTTGTGCGGGCCCCCGTCAATTCCTTTGAGTTTCAGTCTTGCGACCGTACTCC CCAGGCGGAGTGCTTAATGCGTTAGCTGCAGCACTAAGGGGCGGAAACCCCCTAACACTTAGCACTCATCGTTTACGGCGTGGAC TACCAGGGTATCTAATCCTGTTCGCTCCCCACGCTTTCGCTCCTCAGCGTCAGTTACAGACCAGAGAGTCGCCTTCGCCACTGGT GTTCCTCCACATCTCTACGCATTTCACCGCTACACGTGGAATTCCACTCTCCTCTTCTGCACTCAAGTTCCCCAGTTTCCAATGA CCCTCCCCGGTTGAGCCGGGGGCTTTCACATCAGACTTAAGAAACCGCCTGCGAGCCCTTTACGCCCAATAATTCCGGACAACG CTTGCCACCTACGTATTACCGCGGCTGCTGGCACGTAGTTAGCCGTGGCTTTCTGGTTAGGTACCGTCAAGGTACCGCCCTATTCGAACGGTACTTGTTCTTCCCTAACAACAGAGCTTTACGATCCGAAAACCTTCATCACTCACGCGGCGTTGCTCCGTCAGACTT TCGTCCATTGCGGAAGATTCCCTACTGCTGCCTCCCGTAGGAGTCTGGGCCGTGTCTCAGTCCCAGTGTGGCCGATCACCCTCT CAGGTCGGCTACGCATCGTTGCCTTGGTGAGCCATTACCTCACCAACTAGCTAATGCGCCGCGGGTCCATCTGTAAGTGGTAGC CGAAGCCACCTTTTATGTTTGAACCATGCGGTTCAAACAAGCATCCGGTATTAGCCCCGGTTTCCCGGAGTTATCCCAGTCTTA CAGGCAGGTTACCCACGTGTTACTCACCCGTCCGCCGCTAACATCAGGGAGCAAGCTCCCATCTGTCCGCTCGACTTGCATGAT AGCAAGCCCCCCCG |
| Strain Morphology Photos | |
| Morphological Description | round;light yellow;edge neatly;small;steamed bun shaped;slippy;sticky;Rod;no spore |